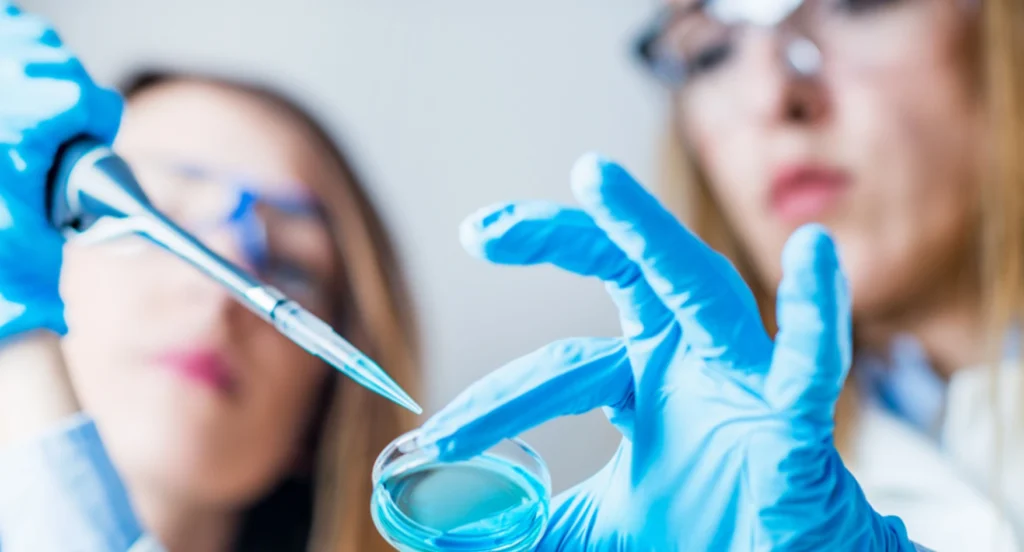

Hiring Smarter During Economic Uncertainty: How Contract Staffing Strengthens Life Sciences Teams
Economic shifts create ripple effects across every industry, but life sciences organizations face unique challenges: Yet during periods of economic uncertainty, many companies freeze hiring or reduce headcount to control costs—leaving critical programs under‑resourced. Forward‑thinking life sciences companies understand that agility is the key to staying competitive. Pausing hiring altogether risks project delays and compliance […]